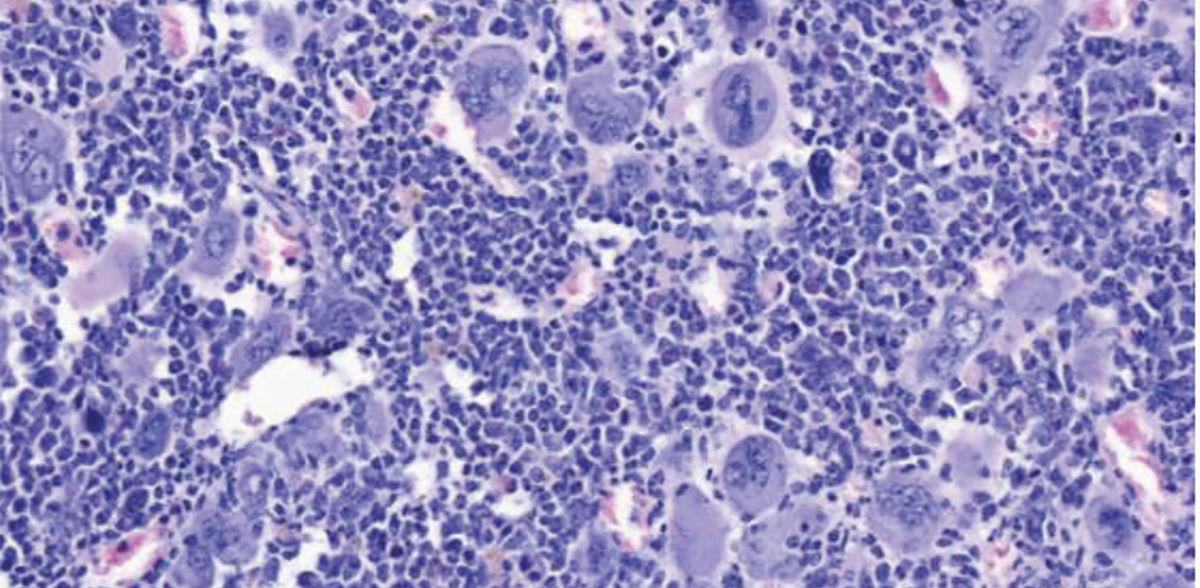
Innere Medizin V / MUI

NLRP3 drives chronic blood cancer
In certain blood cancers, inflammatory processes in the bone marrow lead to life-threatening scarring
Advertisement
Myeloproliferative neoplasms (MPN) are blood cancers characterized by an overproduction of blood cells. These diseases usually occur from the age of 60+ and can be well controlled over a long period of time. MPNs become particularly dangerous after the transition to myelofibrosis - a life-threatening scarring of the bone marrow. To date, an allogeneic stem cell transplant offers the only prospect of a cure for affected patients. "We urgently need new therapy concepts. Stem cell transplantation is associated with too high a risk for many patients due to their advanced age or concomitant diseases," explains Dominik Wolf, Director of the Department of Internal Medicine V (Haematology and Oncology) at the Medical University of Innsbruck, the background to a high-ranking research paper just published in the journal Nature Communications, which he designed and carried out together with Lino Teichman and Miriam Körber from the UKBonn. "In this work, we show a possible new therapeutic concept that should be further developed clinically," says Wolf, who is the last and corresponding author together with Lino Teichmann. The scientists have succeeded in inhibiting NLRP3 inflammasone in an animal model, thereby achieving significant improvements in the course of the disease: Bone marrow scarring and splenomegaly regressed and the blood count improved.
Specifically, the authors investigated the mechanisms of the inflammatory response in MPN, as this leads to many clinical symptoms and ultimately also to bone marrow scarring. The NLRP3 inflammasome is a sensor for danger signals that controls inflammatory processes in the body and whose significance has already been studied in detail in chronic inflammatory diseases such as atherosclerosis, gout and type 2 diabetes. In MPN, the inflammation in the malignant, but also in the accompanying, still healthy blood cells is triggered by a genetic driver mutation, with the activating mutation JAK2V617F playing a central role.
"For the first time, we have investigated the functional role of the NLRP3 inflammasome for the inflammatory response in myeloproliferative neoplasms," says first author Ruth-Miriam Körber from the University Hospital Bonn. In collaboration with the German Study Group of MPN (GSG-MPN), the physicians analyzed a large number of samples and mapped the inflammatory responses before using various techniques to detect the activation of the NLRP3 inflammasome in the patients and also in the MPN animal model.
"We worked closely with Eicke Latz, head of the German Rheumatism Research Center in Berlin, who provided us with various tools. This enabled us to show that these inflammatory factors really are produced in dependence on NLRP3. It was particularly interesting that we were able to inhibit NLRP3 genetically in knockout mice and also with the help of a novel and specific NLRP3-inhibiting drug," says Wolf, referring to a possible therapeutic approach. Thanks to IFM-2384, a substance that was also provided by Eicke Latz, a significant improvement was achieved in the animal model. "The bone marrow scarring and the usually very pronounced splenomegaly decreased. We were also able to improve the blood count," says Wolf.
In a more in-depth analysis, the researchers saw that the overproduction of platelets in particular was significantly reduced as a result of NLRP3 blockade. "The NLRP3 inflammasome plays a major role as a danger sensor. In the event of acute stress - such as an infection - a rescue mechanism is triggered in our body, as a result of which a large number of platelets are produced very quickly," says Teichmann. Together with Wolf, he has been studying the regulation of inflammatory processes in hematological diseases for many years. "NLRP3 is obviously very important in this very complex inflammatory process," says Wolf.
Just a few days ago, the Innsbruck oncologists led by Dominik Wolf were awarded a top-class HOPE project as part of EP PerMed. In collaboration with colleagues from other centers in Austria and Germany, they will advance the high-resolution mapping of myeloproliferative neoplasms and investigate NLRP3-dependent inflammatory mechanisms in more detail.
Note: This article has been translated using a computer system without human intervention. LUMITOS offers these automatic translations to present a wider range of current news. Since this article has been translated with automatic translation, it is possible that it contains errors in vocabulary, syntax or grammar. The original article in German can be found here.
Original publication
Ruth-Miriam Koerber, Calvin Krollmann, Kevin Cieslak, Elisabeth Tregel, Maria L. Saenz, Tim H. Brümmendorf, Steffen Koschmieder, Martin Griesshammer, Ines Gütgemann, Conny K. Baldauf, Thomas Fischer, Peter Brossart, Carl Christian Kolbe, Eicke Latz, Dominik Wolf, Lino L. Teichmann; "NLRP3-induced systemic inflammation controls the development of JAK2V617F mutant myeloproliferative neoplasms"; Nature Communications, Volume 16, 2025-11-26